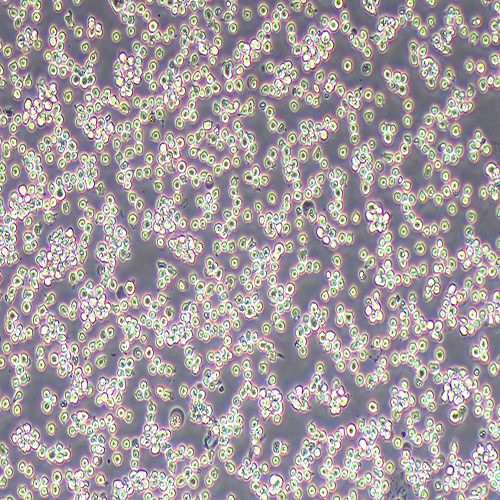
SU-DHL-6人大细胞淋巴瘤细胞

网站主页
SU-DHL-6人大细胞淋巴瘤细胞
SU-DHL-6人大细胞淋巴瘤细胞
SU-DHL-6人大细胞淋巴瘤细胞
询价
1瓶/管
起订
福建 更新日期:2023-09-13
产品详情:
- 中文名称:
- SU-DHL-6人大细胞淋巴瘤细胞
- 产品类别:
- 细胞系 人源细胞系
- 货号:
- IM-H481
- 规格:
- 1×106cells/T25或1mL冻存管
公司简介
厦门逸漠生物科技有限公司(Xiamen Immocell Biotechnology Co.,Ltd.)坐落于厦门国家留学创业园(翔安)产业园,是一家专注于细胞生物学领域新产品、新技术开发的高新技术企业。公司产品涵盖:细胞系、原代细胞、标记细胞、耐药细胞、免疫细胞及胎牛血清、培养基、胰酶、双抗、无血清冷冻液、支原体/黑胶虫清除剂、细胞因子等产品,提供细胞形态和免疫相关检测、流式细胞检测 、细胞学服务、分子生物学检测等多种技术服务。
逸漠生物(IMMOCELL)拥有一支具有深厚造诣和丰富经验的高端技术人才,建设了高规格的研发实验室与生产车间,建立了规范的研发、生产、销售、客服管理体系。公司与国内外多家医院、高等院校、科研院所、生物医药公司建立了良好的合作关系,赢得了良好的市场声誉和广泛的客户认可,努力成为生命科学界可靠的合作伙伴和坚强的技术后盾。
| 成立日期 | (7年) |
| 注册资本 | 1000万 |
| 员工人数 | 50-100人 |
| 年营业额 | ¥ 300万-500万 |
| 经营模式 | 试剂 |
| 主营行业 | 生化试剂,细胞培养 |
SU-DHL-6人大细胞淋巴瘤细胞相关厂家报价
-

- SU-DHL-6(人淋巴瘤细胞)
- 澳培赛生物科技(上海)有限公司 VIP
- 2026-04-17
- ¥1680
-

- SU-DHL-6人B细胞淋巴瘤细胞
- 上海雅吉生物科技有限公司 VIP
- 2026-04-18
- ¥1800
-

- 人大细胞淋巴瘤细胞;SU-DHL-6
- 上海博湖生物科技有限公司 VIP
- 2026-04-17
- ¥5000